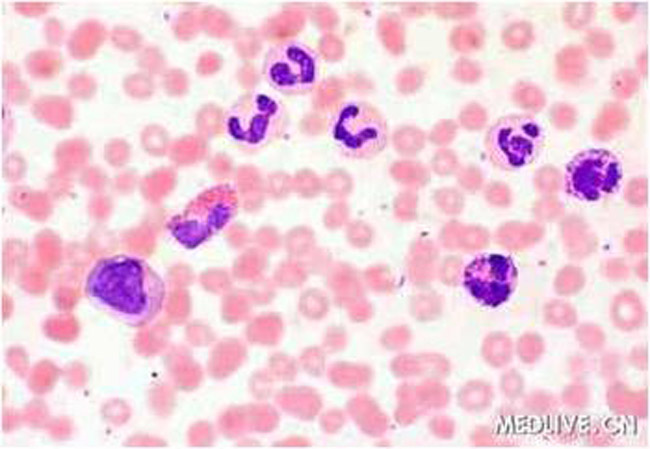

骨髓细胞形态学检查,一直以经典的骨髓穿刺涂片观察分析为最重要和最基本的检查手段,此种检查方法操作简便,涂片内细胞形态良好,易于识别各系列不同发育阶段的血细胞和巨幼细胞,细胞化学染色和免疫细胞化学染色也易于进行。但其不足主要是穿刺过程中易受骨髓干抽和稀释的影响,难以真实反映骨髓增生情况,以及无法判断血细胞、脂肪细胞、骨小梁、血管构型和结缔组织基质间的解剖学关系等。
骨髓活体组织检查简称骨髓活检,是近十多年来取得突破性进展的一种骨髓组织形态学检查方法,它受干抽和稀释的影响小,能通晓骨髓组织病理学全貌,对某些血液疾病、骨髓局灶性病变为特征的疾病,如再生障碍性贫血、骨髓增生异常综合症、骨髓纤维化、淋巴瘤、多发性骨髓瘤、转移瘤、淀粉样变性等,这些疾病做骨髓活检尤其重要。近年来,骨髓涂片细胞形态学检查与骨髓活检切片组织学检查的密切结合,综合分析,大大提高了临床血液病的诊断水平。
一、骨髓针刺活检的取材
骨髓活检取材常采取髂后上棘进行。皮肤经消毒、局部麻醉后,将套上针芯的骨髓活检针加压刺过皮肤,进入骨皮质,感觉阻力减弱再推进1cm左右,抽出针芯,骨髓抽取涂片;套上活动套管,插回针芯,再将活检针推进2-3cm,针管顺时针和逆时针各旋转3-5圈后,退出针管。也可以在同一皮肤进针点,于抽吸处旁开1-2cm的另一方向再做针刺活检。

1.骨髓活检示意图
二、骨髓活组织标本的制备和染色
20世纪80年代初,国外研究者在进行骨髓活检时,用塑料包埋半薄切片技术代替了石蜡包埋技术,这样处理的标本细胞收缩少,切片薄而利于观察细胞内部结构,其主要制备程序包括固定、脱水、塑料包埋以及切片。
骨髓活组织切片的染色除可采用常规的吉姆萨染色、May-Grvnmald
Giemsa(MGG)染色、苏木素-吉姆萨-酸性品红(HGF)染色以及苏木素-伊红(HE)染色外,还可进行一些特殊染色,如Gomori网状纤维染色、Masson胶原纤维染色、淀粉样物质染色等。此外,骨髓活组织也可以进行组织化学染色,如铁染色、过碘酸-雪夫(PAS)、过氧化物酶(POX)染色,以及免疫酶染色,检测各种血细胞的标志性分化抗原等。

2.骨髓活检染色图
三、骨髓活组织切片的血细胞定位
骨髓组织由实质和间质两部分组成,前者为造血细胞,包括各阶段的粒系、红系、巨核系细胞以及淋巴细胞、单核细胞等。骨髓间质由网状-巨噬细胞以及形成网眼的网硬蛋白纤维支架,再加上血管系统和脂肪细胞组成,主要对造血细胞起到支持和营养作用。
在正常的骨髓活检切片中,具有严格的局部解剖和血细胞定位。红系细胞在骨髓组织中成簇存在,位于小梁间区静脉窦四周,其中央由一至两个巨噬细胞,周围围绕着几层幼稚的有核红细胞,内层的幼红细胞较外层更幼稚,这种结构称为幼红细胞岛或幼红细胞簇。原始粒细胞和早幼粒细胞一般单个散在分布,分布于骨小梁旁区,随着发育成熟,逐渐向小梁间区移动,自晚幼粒以下阶段的细胞向静脉窦移动,最终释放入血。
在正常情况下,骨小梁间区没有成簇的幼稚粒细胞分布。当小梁旁区或间区出现3-5个以上的原始和早幼粒细胞聚集成簇,称为未成熟前体细胞异常定位,这是骨髓增生异常综合症的组织病理学特征。
巨核细胞位于小梁间区,在血窦附近单个存在,不发生群集现象,数量为7.6±2.7个mm2,即在50个高倍镜视野有30-60个巨核细胞。
淋巴细胞、浆细胞、单核细胞常定位于造血组织的小动脉和小静脉四周。

3.急性白血病
四、骨髓活检切片的观察内容
骨髓组织活检切片的观察内容主要包括:骨小梁-骨髓造血组织-脂肪组织的全面观察;造血细胞的形态与定位;间质结构的观察包括脂肪、纤维组织、血管与静脉窦、网状-巨噬细胞等;切片内有无人为所导致的骨髓形态改变以及外来恶性肿瘤细胞等。
读片步骤大致如下:
于低倍镜下观察切片取材、染色是否满意,然后再接目镜(10×),装入5mm×5mm的网形目测测微器。
以计点法算出切片内三种主要组织构形的测定值,一般造血组织所占(40±9)Vol%,脂肪组织占(28±8)Vol%,骨小梁占(26±5)Vol%,再按照造血组织所占比例判断骨髓增生程度。在骨髓切片中,如75%以上成分为造血细胞,即可判定为增生明显活跃或极度活跃,如70%以上成分是脂肪细胞组成,即可判定为增生减低。
观察切片内红系、粒系和巨核系造血细胞的分布与定位、有无幼稚细胞的过度增生及位置异常,并算出粒/红比值。
巨核细胞的形态观察与描述,必要时需测定巨核细胞数,即个数/m㎡骨髓面积或个数/100m㎡骨髓面积。较简便的方法是计算10个低倍镜(LPF)视野内细胞的平均数,正常为8-15个/LPF。
注意淋巴细胞、浆细胞和嗜酸性颗粒细胞的形态和增生情况。
肥大细胞的观察与描述,必要时可测定肥大细胞数。
全面观察骨小梁是否有萎缩、变细和侵蚀破坏,注意有无骨内膜细胞、原始(成)骨细胞以及破骨细胞的增生。
观察有无间质的异常,如脂肪细胞坏死、血管系统的异常、红细胞渗出、间质水肿、肉芽肿和胶状变性等。
观察Gimori染色切片上有无网硬蛋白纤维增多,必要时进行Masson胶原纤维三色染色。
贫血患者应常规做切片铁染色的检查,进行细胞内(包括幼红细胞和网状-巨噬细胞)观察Gimori染色切片上有无网硬蛋白纤维增多,必要时进行Masson胶原纤维三色染色。
11、贫血患者应常规做切片铁染色的检查,进行细胞内(包括幼红细胞和网状-巨噬细胞)含铁血黄素量的判断。

4.多发性骨髓瘤
五、骨髓活检切片观察的结论
综合分析骨髓切片内所得资料信息,再结合骨髓涂片、血片检查以及其他实验室检查结果,可得出以下结论:
如果活检切片内出现显著的特征性改变,且与骨髓抽取物涂片完全吻合,即可得出明确的诊断性意见,例如骨髓组织学检查符合急性再生障碍性贫血的诊断。
如果切片内出现某种非特异性组织形态的改变,而不能做出肯定或否定意见,可直接描述组织形态学所见,报告者可提出一些补充检查建议。
当切片活组织象在正常范围内,可报告为“正常或大致正常的骨髓活组织象”。
六、骨髓活检的临床价值
全面了解骨髓的组织结构、间质成分的组织病例学面貌,准确判断骨髓增生程度、粒/红比值及骨髓内铁储存情况,对于某些血液病,如再生障碍性贫血、缺铁性贫血及骨髓增生异常综合征等有明确的诊断价值。
发现骨髓穿刺涂片检查不易发现的病理变化,对某些仅能导致骨髓局部病变为特征的疾病,如骨髓纤维化、骨髓坏死、淀粉样变性、肉芽肿病及多发性骨髓瘤等,骨髓活检尤为重要。
为明确“干抽”原因,探讨其是否为骨髓增生低下、骨髓纤维组织增生或髓腔因增生极度活跃引起“塞实”所致,骨髓活检具有重要意义。
对各种急、慢性白细胞和骨髓增生异常综合征的确诊和预后判断有重要价值。
对骨髓转移癌、恶性组织细胞病、戈谢氏病和尼曼-匹克病等的诊断阳性率比骨髓涂片高。
协助诊断慢性骨髓增生性疾病,如真性红细胞增多症、原发性血小板增多症等。
七、常见血液系统疾病的骨髓活检特点
1. 红细胞系增生异常
骨髓活检标本中粒/红比值的正常参考区间1.5-3.5:1,小于1.5:1,且细胞增生明显活跃,即为红细胞系增生活跃。红细胞系增生活跃的常见疾病有缺铁性贫血、溶血性贫血、巨幼红细胞贫血等;红细胞系增生减低的常见疾病有再生障碍性贫血和纯红细胞再生障碍性贫血等。
缺铁性贫血:骨髓切片显示增生活跃或明显活跃,以下不同阶段的红系细胞增生为主,幼红细胞岛增多,粒系和巨核系细胞无明显异常,铁染色显示缺铁现象,骨髓储存铁几乎消失。与骨髓抽吸组织相比,骨髓组织塑料包埋切片的铁染色效果更佳。
再生障碍性贫血:由于骨髓涂片取材少,骨髓活检对再障的诊断优于骨髓涂片,确诊再障应常规进行骨髓活检。骨髓切片显示:造血组织面积缩小,增生重度减少,骨髓主要成分由脂肪组织构成,常有脂肪组织液化性坏死。造血细胞减少,可见残存的孤立性幼红细胞岛,常局限于静脉窦附近,也可见散在、灶性的粒细胞增生,巨核细胞显著减少或缺如。间质水肿,可见坏死细胞、毛细血管和窦状系坏死,非造血细胞增加,如淋巴细胞、浆细胞、肥大细胞、巨噬细胞增加。

5.再生障碍性贫血
2. 粒细胞系增生异常
如果粒/红比值升高,而且骨髓切片中原始细胞占优势,以急性白血病最为常见。
急性粒细胞白血病:骨髓增生明显活跃或极度活跃,造血组织高达100%,脂肪组织减少或消失。造血组织中可见大量的白血病细胞,不同亚型白血病的原始细胞(或早期幼稚细胞)的类型及比例不尽相同,白血病细胞的形态异常,如核仁明显,胞质少,可见病理性核分裂象。红系和巨核系增生受抑或缺如。白血病细胞弥漫侵润,骨髓腔完全被白血病细胞充填,骨小梁萎缩变细。骨髓切片还可对白血病的疗效做出评价,如骨髓切片显示原始细胞与早幼细胞集簇,类似于MDS所见ALIP,即使骨髓涂片检查显示达完全缓解,患者仍需继续巩固性化疗。
慢性粒细胞白血病:骨髓增生极度活跃,粒系细胞极度增生,粒/红比值可达 10~50:1。 粒系各阶段细胞均有增多,以中幼粒为主,原始粒及早幼粒不超过10%,嗜酸和嗜碱性粒细胞亦有所增加,巨核细胞增加,但形态正常。如果慢性期患者切片内检出原始粒细胞与早幼粒细胞的非小梁旁区灶异常定位,并逐渐深入间区中央主质内,提示急变即将来临。
3. 淋巴细胞系增生异常
恶性淋巴瘤分为霍奇金病和非霍奇金病。骨髓活检对恶性淋巴瘤分型以及是否累及骨髓是必不可少的。霍奇金病骨髓侵润活检可发现RS细胞(Reed-Sternberg cell)即“镜影细胞”,多数瘤细胞分布于小梁旁区或小梁间区;非霍奇金淋巴瘤的瘤细胞多数呈灶状分布,侵润病变区均见纤维增生,即合并骨髓纤维化,较典型瘤细胞可分为四种类型,淋巴细胞型、组织细胞型、混合型和未分化型。

6.霍奇金淋巴瘤
4. 其他造血系统疾病
骨髓增生异常综合征(MDS):大多数病例骨髓增生活跃或明显活跃,造血细胞病态造血是本病的主要特点:①红系病态造血,红细胞系增生活跃,易见核分裂象、核发育失调、巨幼样变等,出现同一分化阶段的原始红细胞岛;②粒细胞生成异常,出现未成熟前体细胞异常定位(ALIP)是MDS的骨髓病理学特征。粒细胞的形态异常,可见核浆发育不平衡、巨幼样变、环形核、双核及三核粒细胞等;③巨核系细胞病态造血,MDS骨髓组织学特征之一是检出不典型微巨核细胞,呈α-NAE强阳性。
多发性骨髓瘤:骨髓增生明显活跃,造血组织增加,脂肪组织正常或减少,小梁间区有不同分化程度的浆细胞弥漫性侵润,原始、幼稚浆细胞沿骨内膜成簇或弥漫性分布于血管周围、小梁旁区,破骨细胞增多,骨小梁破坏。当瘤细胞分化较差时,细胞形态异常,核仁明显,胞质嗜碱性,胞质及核内常可找到嗜酸性包涵体,为识别浆细胞的特征之一;骨髓间质水肿、渗出。
恶性组织细胞病:骨髓增生活跃或明显活跃,造血组织和脂肪组织容量大致正常,早期骨髓组织结构多数正常,随病情进展骨髓正常结构破坏;红细胞系、粒细胞系及巨核细胞形态与数量基本正常,肿瘤性组织细胞可分为五种类型,即淋巴样组织细胞、单核样组织细胞、吞噬性组织细胞、异常组织细胞及多核巨细胞型组织细胞,其中具有较高诊断价值的是异常组织细胞及多核巨细胞型组织细胞。
骨髓纤维化:骨髓组织纤维增多,纤维变性物质有网硬蛋白和致密的胶原纤维混合形成,脂肪组织减少,髓腔可见成纤维细胞弥漫分布,造血组织萎靡,骨髓涂片常“干抽”,红系、粒系细胞减少,病态巨核细胞增多或正常,常聚集成簇,且具明显多形性。
7.慢性髓系白血病
八、骨髓活检的优缺点
1、优点:
1)保持造血组织的天然结构,便于判断红髓和脂肪组织的比例。
2)可全面了解骨髓增生程度,有核细胞密度及其布局。
3)可避免骨髓稀释。
4)对骨髓纤维化、毛细胞白血病有确诊作用,能提示骨髓增生异常综合症向急性粒细胞白血病的转化,对于“干抽”有鉴别作用。
2、缺点:
1)有核细胞群集,不易区分原始和幼稚细胞的类型。
2)难以观察细胞内微细结构。
3)细胞化学染色结果难以量化。
九、骨髓活检的适应症和禁忌症
1、适应症
1)多次事故穿刺抽吸取材失败。
2)血象显示为全血细胞减少,多次骨髓穿刺为骨髓增生减低,怀疑为再生障碍性贫血、骨髓增生异常综合症及低增生性白血病患者。
3)临床疑为罹患骨髓纤维化、恶性淋巴瘤、多发性骨髓瘤、淀粉样变性、转移瘤等患者。
4)对急性白血病的诊断与化疗效果的判断,以及骨髓移植前、后动态观察均有重要意义。
2、禁忌症
血友病患者禁做骨髓穿刺。胸骨畸形者不宜做胸骨穿刺。有出血倾向者操作时应特别注意。(基础研究室 李军 魏曙亚 内三科 张燕军)